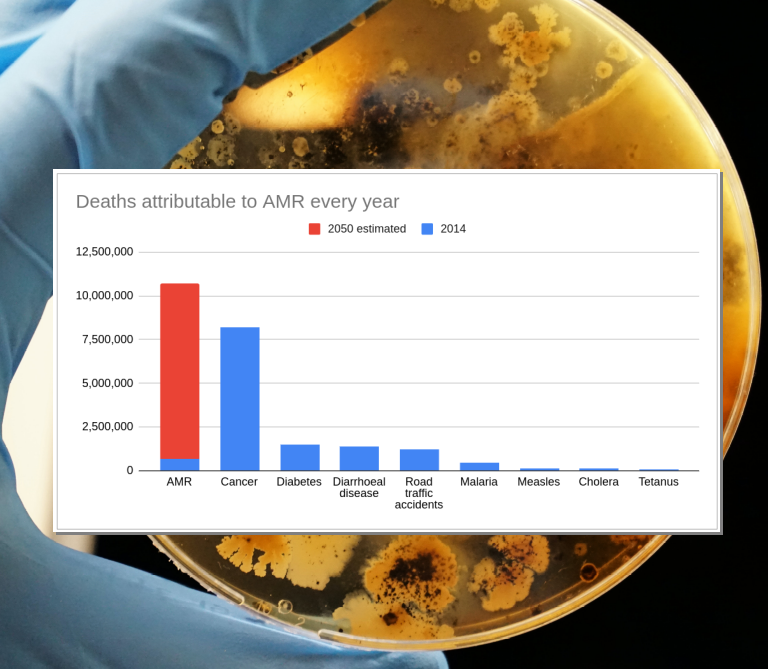
The global response to AMR (not enough)

Built environment/wellness
Our cities, buildings and man-made environment plus issues around health and wellness
We have enough materials for the green revolution BUT …
To many sustainability specialists, mining is not green, it's brown. It's sometimes thought of as being up there with O&G, some Heavy Industry, Tobacco and Coal. But, we cannot “fix” the problem through exclusions, mining is just too important.
The global response to AMR (not enough)
Antimicrobial resistance is acknowledged globally as a significant macro threat. But how effective are national action plans?
'The Loop' supporting the 20-minute city
Creating the right infrastructure to reduce the distance that people need to travel can be important in decarbonising transportation.
Loyalty cards - the new early warning system?
Early diagnosis in many diseases can be the difference between life or death. Could useful data come from an unexpected source?
archiTECHture
The built environment is an important decarbonisation (and efficiency) problem. Tech innovations can help.
Are green buildings more valuable?
Apparently buildings with better sustainability credentials are achieving markedly higher capital values and rents
Hospitals and sustainability
Hospitals and healthcare facilities help sustain human life. But at what cost to the environment?
Energy efficiency is the first step
The cheapest and greenest energy is the energy we don't use. Calls for a national 'war effort' on energy efficiency.
Finding hidden pollution on the tube.
Pollution on the London Underground may be more harmful than previously thought, but the solution may be pure magnetism.
AMR - Spoiling the party with physics and material science
Antimicrobial Resistance (AMR) is a macro threat to the sustainability of the human race and other species. Bringing together different solutions we should be able to continue to enjoy the benefits of our microbe partners whilst avoiding their darker side.
PM2.5 linked to heart attacks
Air pollution increasing the incidence of cardiac arrests, even if that exposure is short-term.
AMR, climate change and biodiversity loss
Sustainability themes are rarely mutually exclusive. Three big ones are inextricably linked.